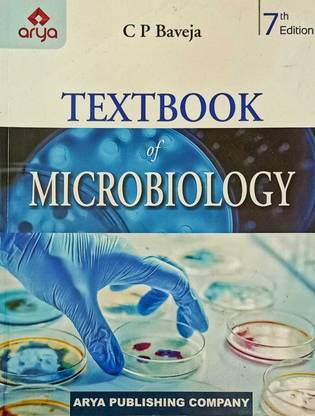

Textbook Of Microbiology (Paperback, C. P. Baveja)
Share
Textbook Of Microbiology (Paperback, C. P. Baveja)
4.8
6 Ratings & 1 Reviews₹1,650
Available offers
T&C
T&C
T&C
T&C
Delivery
Check
Enter pincode
Delivery by27 Oct, Monday
?
View Details
Highlights
- Author: C. P. Baveja
- 690 Pages
- Language: English
- Publisher: Arya Publishing Company;
Services
- Cash on Delivery available?
Seller
Description
Textbook of Microbiology
Read More
Specifications
| Book |
|
| Author |
|
| Binding |
|
| Publishing Date |
|
| Publisher |
|
| Edition |
|
| Number of Pages |
|
| Language |
|
| Genre |
|
| Book Subcategory |
|
Manufacturing, Packaging and Import Info
Ratings & Reviews
4.8
★
6 Ratings &
1 Reviews
- 5★
- 4★
- 3★
- 2★
- 1★
- 5
- 1
- 0
- 0
- 0
5
Brilliant
Very helpful thank u filpkart
READ MORESwetha nagini Bonthu
Certified Buyer, Amalapuram
Jul, 2023
0
0
Report Abuse
Be the first to ask about this product
Safe and Secure Payments.Easy returns.100% Authentic products.
Back to top




